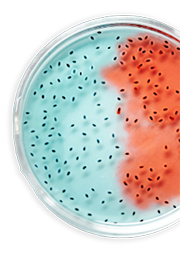

ការស្រាវជ្រាវ និងការអភិវឌ្ឍ
យើងជឿជាក់លើសមាសភាគសំខាន់នៃភាពជោគជ័យ និងកំណើននិរន្តរភាពនៃធុរកិច្ចផលិតផលស្លាកយីហោរបស់យើង ហើយដែលយើងមានសមត្ថភាពក្នុងការអភិវឌ្ឍ និងផ្ដួចផ្ដើមផលិតផលថ្មីៗចូលទៅក្នុងផលប័ត្ររបស់យើង។
យើងធានាថាផលិតផលនីមួយៗរបស់យើងសុទ្ធតែឆ្លងកាត់ចរន្តតាមដានយ៉ាងតឹងរឹងពីការកំណត់អត្តសញ្ញាណផលិតផល រហូតដល់ការអភិវឌ្ឍ ការផលិត និងទីបំផុតការចូលទៅក្នុងទីផ្សារ។